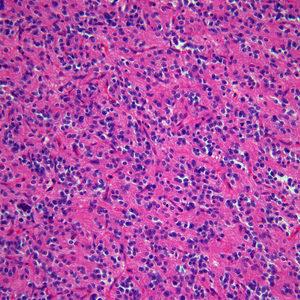

- Projects 0
University Students passionate about Machine Learning, Deep Learning and Artificial Intelligence, and seeking to advance these fields

University Students passionate about Machine Learning, Deep Learning and Artificial Intelligence, and seeking to advance these fields with amazing new and innovative Deep Neural Network Models and AI Applications


Deep Learning Researcher

I am a Final year undergraduate student in Computer Science and Engineering at Siliguri Institute of Technology (SIT), Siliguri, West Bengal.
Jalpaiguri, West Bengal

Founder of Peter Moss Leukemia AI Research & the Peter Moss Acute Myeloid / Lymphoblastic Leukemia AI Research Project. Also an Intel Software Innovator in the fields of AI, IoT and Virtual Reality. Self-taught developer with experience in disruptive technologies such as the Internet of Things, Artificial Intelligence (Machine Learning, Deep Learning, Natural Language Understanding & Computer Vision), automation and BioHacking. In addition to disruptive technologies, I have experience in hybrid web applications & content management systems, mobile & desktop applications, business administration systems & social media marketing. I use these skills to provide free information and services for those wanting to learn how to program or learn about technology. I began his journey utilizing Artificial Intelligence for cancer detection in 2018 with Breast Cancer AI, before creating the Peter Moss Acute Myeloid / Lymphoblastic Leukemia AI Research Project when his grandad, Peter Moss, was diagnosed with AML in late 2018.


I am a Technology Evangelist, personally interested in System Integrations culminated by Artificial General Intelligence
Unknown

Am a highly motivated person.I purpose to achieve my full potential in my chosen academic field and undertakings,always aiming to apply my knowledge,training, and skills to improve myself and my environment,with the goal of leaving all that i interact with,all the better of my involvement.
Nairobi, Nairobi County

Guwahati, Assam

A Design Thinker at heart. Currently working as Ecosystem Engagement Manager at Beahead Pvt. Ltd. living in Bengaluru, India. I love helping startups scale in User Experience (UX). Read more at: www.about.me/siddhantagarwal
Delhi

CSE graduate, with experience in Internet of Things and Quadcopter development. Love learning new disruptive technologies, and have worked with 2 startups in the past. Currently working in Ericsson R&D, and concurrently chairing a team of 6 people as part of Ericsson IT’s Innovation Competence Center Intel Software Innovator in Android, IoT and RealSense. Ex-Moderator and Judge for Microsoft’s Virtual Academy, and Imagine Cup 2016: Break Into Code challenge respectively. I'm also a regular contributor to Github (projects/patches), Hackster.io (projects), Microsoft's Technet, and my own blog - http://theaggregateindian.com/


Vincenzo is a graduate student focusing on machine learning and its applications. He wants to use AI to help musicians compose new songs and to prevent emergency situations with smart video-surveillance systems. He is also an IoT enthusiast.
Turin, Piedmont

Virtual/Augmented Reality and Artificial Intelligence Enthusiast
Unknown

New Delhi, Delhi

Unknown

Created: 07/27/2019

Created: 11/26/2017

Created: 06/13/2019

Created: 02/21/2018

Created: 03/07/2018

Created: 06/09/2019

Created: 07/27/2019

Created: 07/18/2018

Created: 08/22/2018

Created: 07/21/2018

Created: 07/21/2018
Created: 05/16/2019

Created: 03/06/2019

Created: 04/03/2019

Created: 05/15/2018